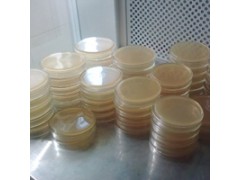

产品简介
脑心浸液琼脂(BHI)培养基 广锐生物坚守品质、锐意进取,提供微生物干粉、成品培养基、动植物培养基、细胞培养基、食品安全快速检测试剂和各种配套的原料,提供高品质培养基产品。
公司简介
上海广锐生物科技有限公司,实验室、科研院校供应商,致力于发展酶联免疫领域,多年来坚守产品质量的可靠、稳定。并严格秉承“专业、诚实、守信、创新”全过程、全方位的质量监控检测,从包装到品质,从产品到服务,每个环节,我们都严控质量关,为科研老师们提供各种不同试验研究,从而达到试验目的。
产品范围:
一、试剂盒种类:细胞因子Elisa试剂盒、传染病检测Elisa试剂盒、肝纤维化系列Elisa试剂盒、内分泌系列Elisa试剂盒、特种蛋白检测Elisa试剂盒、心肌梗赛检测Elisa试剂盒、优生优育检测Elisa试剂盒、肿瘤标志物检测Elisa试剂盒、食品安全检验Elisa试剂盒、动植物类检测Elisa试剂盒;
二、免疫组化试剂盒、生物试剂、化学试剂、标准品、对照品、单抗|多抗体、干粉培养基、一次性培养平板、单种微量生化管、微生物测试纸片等科研产品。
三、技术服务要求:规范、高效。
广锐生物实验用品供应商,始终坚持“专注品质、信守承诺、锐意进取”,满足于每一位老师的实验要求,期待我们共赢发展!
展开
产品说明
脑心浸液琼脂(BHI)培养基 包装:100g、250g、500g
性质:粉末、纸片、生化管
现货:没现货可现做
灭菌:高压蒸汽灭菌器、电热恒温干烤箱(干热灭菌用)。
微生物保存温控器械—培养箱、培 养 间、冰箱、恒温水浴箱;
脑心浸液琼脂(BHI)培养基 常用仪器:电动匀浆仪、离心机、薄膜过滤装置、显微镜、载玻片及容量瓶、滴定管、刻度吸管、试管、锥形瓶、培养皿等常用玻璃仪器。
用途:实验室研究使用
脑心浸液琼脂(BHI)培养基
干粉培养基:有细菌总数,大肠杆菌,金黄色葡萄球菌,沙门氏菌,霉菌酵母菌,李斯特菌等所有细菌的普通培养基和显色培养基。
脑心浸液琼脂(BHI)培养基 库存内其他试剂:
枸橼酸盐斜面厂家甘油磷酸钠厂家
CVT琼脂培养基
大鼠FⅧ-Ag,凝血因子Ⅷ相关抗原Elisa试剂盒
脑浸液(牛)厂家
人AECA,抗内皮细胞抗体Elisa试剂盒
卵黄琼脂培养基基础厂家
鸡GFAP,神经胶质纤维酸性蛋白Elisa试剂盒
头孢匹胺药敏片
BR
添加于TTC琼脂基础中
小鼠CH50,血清总补体Elisa试剂盒
麦芽浸膏
人AFP-L1,小扁豆素结合型甲胎蛋白/甲胎蛋白异质体1Elisa试剂盒
平板计数琼脂平板厂家
CCDA添加剂厂家
小鼠AmAC-1,巨噬细胞替代激活相关化学因子1Elisa试剂盒
BS
卵磷脂吐温80营养琼
Anti-CDX2(cau-dal-related homeobox trans
cription factor 2)
血平皿 9cm 液体
NAC液体培养基
BR
Anti-CKⅡα/STK(Casein kinase Ⅱα;Serine/Threo
nine Protein KinaseⅡα)
人PGF,血小板生长因子Elisa试剂盒
用于金黄色葡萄球菌增菌培养,每100ml 培养基需另加入1%亚碲酸钠1ml
HE琼脂(HE)厂家
葡萄糖蛋白胨琼脂
氯化钠血琼脂基础厂家
氯化镁孔雀绿肉汤(MM)培养基
Anti-ADNP/NAP (Activity-dependent Neuroprotective protein )
人C-Peptide,C肽Elisa试剂盒
绵羊IL-1β,白介素1βElisa试剂盒

本页产品地址:http://www.geilan.com/sell/show-8515676.html

![]()

 免责声明:以上所展示的[ 脑心浸液琼脂(BHI)培养基]信息由会员[上海广锐生物elisa技术部]自行提供,内容的真实性、准确性和合法性由发布会员负责。
免责声明:以上所展示的[ 脑心浸液琼脂(BHI)培养基]信息由会员[上海广锐生物elisa技术部]自行提供,内容的真实性、准确性和合法性由发布会员负责。